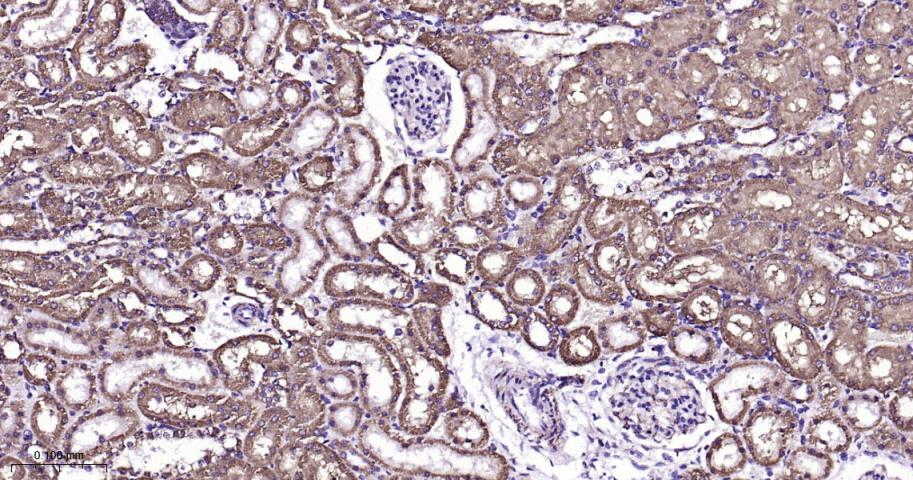
VDAC1 Recombinant Rabbit mAb,

相关产品推荐更多 >

CD62p Rabbit pAb, BF750 conjugated(bs-10770R-BF750)-100ul
¥2980
SRSF1/SF2 Rabbit pAb(bs-19674R)-50ul/100ul/200ul
¥1180
Lumican Rabbit pAb, Biotin conjugated(bs-5890R-Bio)-100ul
¥2980
Cytochrome C Mouse mAb, BF488 conjugated(bsm-33193M-BF488)-100ul
¥2980
FAM134B Rabbit pAb, PE conjugated(bs-13136R-PE)-100ul
¥2980
万千商家帮你免费找货
0 人在求购买到急需产品
- 详细信息
- 文献和实验
- 技术资料
- 应用范围:
产品信息以Bioss网站为准
- 规格:
50ul/100ul/25ul
| 规格: | 50ul | 产品价格: | ¥1400.0 |
|---|---|---|---|
| 规格: | 100ul | 产品价格: | ¥2500.0 |
| 规格: | 25ul | 产品价格: | ¥800.0 |
| 产品编号 | bsm-52251R |
| 英文名称 | VDAC1 Recombinant Rabbit mAb, Mitochondrial Loading Control |
| 中文名称 | 等电压依赖性阴离子通道(内参)重组兔单抗 |
| 英文别名 | voltage-dependent anion channel; hVDAC1; MGC111064; Outer mitochondrial membrane protein porin 1; Plasmalemmal porin; Porin 31 HL; Porin 31HL; Porin 31HM; VDAC 1; VDAC; VDAC1; Voltage dependent anion channel 1; Voltage dependent anion selective channel protein 1; VTA1_HUMAN. |
| 产品应用 | WB=1:500-5000, IHC-P=1:100-500, IHC-F=1:100-500, IF=1:100-500, ICC/IF=1:50-200 Not yet tested in other applications. |
| 交叉反应 | Human, Mouse, Rat |
| 抗体来源 | Rabbit |
| 免疫原 | A synthesized peptide derived from human VDAC1 |
| 亚型 | IgG |
| 性状 | Liquid |
| 纯化方法 | affinity purified by Protein A |
| 克隆类型 | Recombinant |
| 理论分子量 | 32 kDa |
| 浓度 | 1mg/ml |
| 储存液 | 0.01M TBS (pH7.4) with 1% BSA, 0.02% Proclin300 and 50% Glycerol. |
| 研究领域 | Cancer > Cancer Metabolism > Cellular metabolic process Cancer > Cell Death > Apoptosis > Metabolism Cancer > Cell Death > Apoptosis > Mitochondrial Cell Biology > Apoptosis > Mitochondrial Isotype/Loading Controls > Loading Controls > VDAC1 - Mitochondrial Preps Metabolism > Pathways and Processes > Metabolic signaling pathways > Energy transfer pathways > Energy Metabolism Metabolism > Pathways and Processes > Metabolism processes > Apoptosis Metabolism > Pathways and Processes > Mitochondrial Metabolism > Mitochondrial markers Metabolism > Types of disease > Cancer Signal Transduction > Metabolism > Energy Metabolism Signal Transduction > Metabolism > Mitochondrial Signal Transduction > Metabolism > Plasma Membrane > Channels Tags & Cell Markers > Subcellular Markers > Organelles > Mitochondria |
| 亚基 | Interacts with VPS4B. Interacts with CHMP1B. Interacts with CHMP2A; the interaction probably involves the open conformation of (polymerized) CHMP2A. May interact with CHMP3. Interacts with CHMP5; the interaction involves soluble CHMP5. Interacts with IST1. |
| 亚细胞定位 | Cytoplasm. Endosome membrane; Peripheral membrane protein (Probable). |
| 相似性 | Belongs to the VTA1 family. |
| 功能 | Involved in the endosomal multivesicular bodies (MVB) pathway. MVBs contain intraluminal vesicles (ILVs) that are generated by invagination and scission from the limiting membrane of the endosome and mostly are delivered to lysosomes enabling degradation of membrane proteins, such as stimulated growth factor receptors, lysosomal enzymes and lipids. Thought to be a cofactor of VPS4A/B, which catalyzes disassembles membrane-associated ESCRT-III assemblies. Involved in the sorting and down-regulation of EGFR (By similarity). Involved in HIV-1 budding. |
| 保存条件 | Store at -20℃ for one year. Avoid repeated freeze/thaw cycles. The lyophilized antibody is stable at room temperature for at least one month and for greater than a year when kept at -20°C. When reconstituted in sterile pH 7.4 0.01M PBS or diluent of antibody the antibody is stable for at least two weeks at 2-4℃. |
| 注意事项 | This product as supplied is intended for research use only, not for use in human, therapeutic or diagnostic applications. |
| 背景资料 | Voltage dependent anion selective channel protein 1 (VDAC/Porin) belongs to the eukaryotic mitochondrial porin family and forms a channel through the mitochondrial outer membrane and also the plasma membrane. The channel allows diffusion of small hydrophilic molecules; it adopts an open conformation at low or zero membrane potential and a closed conformation at potentials above 30-40 mV. The open state has a weak anion selectivity whereas the closed state is cation selective. VDAC/Porin expression is observed in the heart,liver and skeletal muscle. |
| 应用 | 推荐稀释比例 |
| {WB} | {1:500-5000} |
| {IHC-P} | {1:100-500} |
| {IHC-F} | {1:100-500} |
| {IF} | {1:100-500} |
| {ICC/IF} | {1:50-200} |

风险提示:丁香通仅作为第三方平台,为商家信息发布提供平台空间。用户咨询产品时请注意保护个人信息及财产安全,合理判断,谨慎选购商品,商家和用户对交易行为负责。对于医疗器械类产品,请先查证核实企业经营资质和医疗器械产品注册证情况。
 文献和实验
文献和实验[IF={{ 4.213 }}] {Yang Jiao. et al. Lysine demethylation KDM5B downregulates SIRT3-mediated mitochondrial glucose and lipid metabolism in diabetic neuropathy. DIABETIC MED. 2022 Sep;:e14964} {WB} {Mouse}
[IF={{ 2.9 }}] {Songfeng Chen. et al. Upregulation of mitochondrial PGK1 by ROS-TBC1D15 pathway promotes neuronal death after oxygen-glucose deprivation/reoxygenation injury. BRAIN RES. 2024 Feb;1825:148724} {WB} {Mouse}
[IF={{ 1.7 }}] {Jinhua Wang. et al.Indirubin induces apoptosis in ovarian cancer cells via the mitochondrial pathway.AMERICAN JOURNAL OF TRANSLATIONAL RESEARCH.2024 Oct 15;16(10):6119-6129.} {Western blot} {Human}
 技术资料
技术资料暂无技术资料 索取技术资料





